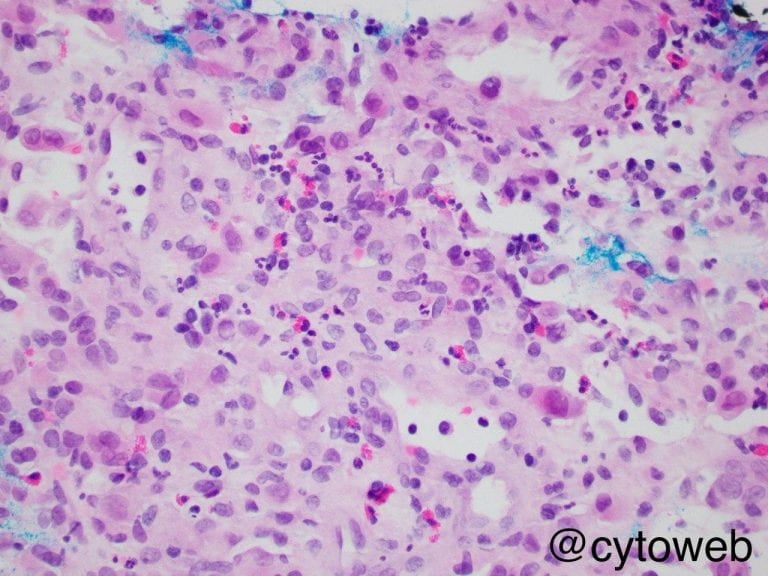

Musculoskeletal 1
A groovy scapular lesion
Clinical history: A 43-year-old lady presented with 3-month history of left shoulder pain. Plain film X-ray shows a well-defined lytic lesion in the left scapula. A CT-guided core biopsy of the lesion is performed and a cytology imprint is shown.
Case writer: Dr Noel Chia